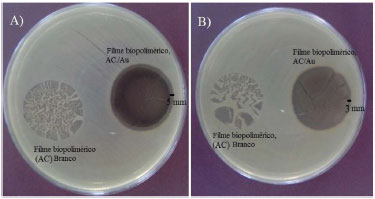

Educação
|
|
| Nanopartículas de Au em líquido iônico suportadas em filmes biopoliméricos: uma aula prática para investigação da atividade antimicrobiana Au nanoparticles in ionic liquid supported on biopolymeric films: a practical lesson for investigation of antimicrobial activity |
|
Camila C. de Quadros; Marcos F. Brunelli; Vinícius W. Faria; Carla W. Scheeren*
Escola de Química e Alimentos, Universidade Federal do Rio Grande, Campus Santo Antônio da Patrulha, Rua Barão do Caí, 125, Cidade Alta, CEP 95500-000, Santo Antônio da Patrulha - RS, Brasil Recebido em 09/02/2016 *e-mail: carlascheeren@gmail.com The synthesis of Au nanoparticles (NPs) in ionic liquid (IL) supported on biopolymers films applied in the investigation of antimicrobial activity was introduced as a new experimental practice for undergraduates in the nanotechnology discipline at the Department of chemistry, at University Federal of Rio Grande- FURG. The Au NPs were synthesized by reduction of tetrachloroauric acid complex trihydrate (HAuCl4.3H2O) in IL 1-n-butyl-3-methyl-imidazolium hexafluorophosphate (BMI.PF6) using sodium borohydride at room temperature. Subsequently, the Au NPs were supported in the biopolymers films using a solution of cellulose acetate dissolved in acetone. The biopolymers films containing supported Au NPs were applied in the investigation of antimicrobial activity against bacteria Escherichia coli e Staphylococcus aureus. INTRODUÇAO A nanociência está ligada à manipulaçao da matéria em escala nanométrica, escala tao pequena quanto à de um bilionésimo do metro (10-9 m). Multidisciplinar a nanociência tem potencial de aplicaçao em diferentes áreas como: biologia, física, química e engenharia.1 A aplicaçao de membranas/filmes biopoliméricos tem atraído a atençao de pesquisadores em diversas áreas, como: biotecnologia, farmacêutica, médica, catálise, eletroquímica e ambiental.2-7 A combinaçao de nanopartículas (NPs) metálicas e filmes poliméricos com atividade antibacteriana têm sido muito estudados, os quais exibem grande atividade tóxica frente a bactérias e outros microorganismos, como fungos e também o sistema humano.8-15 NPs metálicas sao capazes de incapacitar micróbios através da interaçao com algumas enzimas, proteínas e/ou DNA, inibindo a proliferaçao celular ou divisao celular. Para estas aplicaçoes, NPs têm sido suportadas em biopolímeros em várias formas (por ex. cateteres, material dentário, dispositivos médicos, implantes e curativos para queimaduras) com o objetivo de proteger contra a contaminaçao microbiana. Pra aplicaçoes médicas, o acetato de celulose (AC) é um bom candidato, porque este polímero é hidrofílico, nao tóxico, biodegradável e renovável.16 Podemos citar um exemplo, onde tecido de algodao foi usado como suporte para NPs de prata (41 ± 7 nm) com efeito antimicrobiano em bactérias gram-positivas (Staphylococcus aureus) e gram-negativas (Escherichia coli). Filmes poliméricos de acetato de celulose semipermeáveis foram utilizados como suporte para NPs de Pt e Au.17 Entretanto, um filme polimérico pode exibir outras vantagens adicionais como um material com maior capacidade de imobilizaçao e seletividade, reduçao no tamanho de partícula, prevençao da aglomeraçao das NPs e estabelecimento de uma regiao de contato poroso entre as fases líquida e gasosa com a estrutura polimérica.18,19 Recentemente também foi demonstrado que a combinaçao de NPs metálicas estáveis em líquidos iônicos (LIs) com um filme polimérico de celulose pode gerar um material novo e versátil.20 Nestas práticas experimentais, nós demonstramos a combinaçao de NPs de Au sintetizadas em líquido iônico BMI.PF6 suportadas em filme biopolimérico de acetato de celulose com investigaçao em atividade antimicrobiana frente as bactérias S. aureus e E. coli. A combinaçao gerou a formaçao de um material com estrutura porosa com fácil incorporaçao das NPs de Au e boa atividade antimicrobiana. Através da realizaçao dos experimentos propostos neste trabalho é possível evidenciar a abrangência da nanociência em diversas áreas da química: química inorgânica (propriedades), orgânica (líquidos iônicos), físico-química (propriedades óticas e espectroscópicas), analítica (instrumentaçao/espectroscopia) e biologia/bioquímica (atividade antimicrobiana). Os experimentos propostos neste trabalho sao ideais para serem desenvolvidos com alunos do sexto ao oitavo semestre dos cursos de graduaçao.
PARTE EXPERIMENTAL Todas as reaçoes realizadas nos experimentos foram conduzidas ao ar. Os filmes biopoliméricos de acetato de celulose contendo NPs de Au - denominados de AC/Au - foram preparados partindo-se do complexo HAuCl4.3H2O disperso em líquido iônico BMI.PF6 e de soluçao de acetato de celulose dissolvido em acetona. Foram obtidos 900 mg de filme biopolimérico de acetato de celulose contendo 10 mg de NPs de Au. O líquido iônico hexafluorofosfato de 1-n-butil-3-metilimidazólio (BMI.PF6), (Aldrich) foi utilizado na síntese das NPs de Au. Os reagentes, acetato de celulose (Aldrich, 39,8% em peso de teor de acetilaçao) e acetona (Merck, 99,8%) foram utilizados para preparar os filmes biopoliméricos. Todos os outros produtos químicos foram adquiridos a partir de fontes comerciais e utilizados sem purificaçao adicional. Para a realizaçao dos experimentos destacamos a importância do uso dos equipamentos de proteçao individual (EPIs) como: uso do jaleco, luvas e óculos de segurança. Durante o desenvolvimento dos experimentos os alunos devem tomar cuidado ao manusearem o complexo metálico, utilizando sempre luvas. Atençao ao preparo da soluçao polimérica a qual é dissolvida em acetona, usar luvas e óculos de proteçao ao manusear solventes. E atençao ao colocarem os discos dos filmes biopoliméricos nas placas de Petry, pois estes possuem culturas de bactérias, usar luvas e óculos de proteçao. Planejamento experimental A sequência de experimentos apresentada neste trabalho foi idealizada para fornecer aos discentes, de forma simplificada, aspectos práticos da síntese de NPs de Au, assim como da imobilizaçao destas em filmes biopoliméricos e a investigaçao da atividade antimicrobiana. Assim, o experimento aqui exposto tem por objetivo final a produçao de um filme biopolimérico contendo NPs de Au com atividade antimicrobiana. Para a execuçao dos experimentos os autores sugerem quatro aulas práticas de duas horas cada. A primeira aula visa sintetizar as NPs de Au, na segunda aula será preparada a soluçao biopolimérica e os filmes biopoliméricos contendo as NPs de Au suportadas, na terceira aula serao preparadas as placas contendo cultura de bactérias para investigaçao da atividade antibacteriana e na quarta aula serao avaliados os resultados obtidos. Aula prática 1: síntese de NPs de Au em líquido iônico BMI.PF6 Neste experimento, foi preparada uma soluçao dissolvendo borohidreto de sódio (NaBH4), (9,25 mg, 250 mmol) em 2 mL de metanol e disperso em 1 mL de líquido iônico (BMI.PF6). Separadamente, foi preparada uma soluçao contendo o precursor utilizado na síntese de NPs de Au, HAuCl4.3H2O (10 mg, 25 mmoL) dissolvido em 2 mL de metanol e disperso em 1 mL de líquido iônico (BMI.PF6), esta soluçao formada foi agitada a temperatura ambiente por 15 min, formando uma soluçao amarela. Posteriormente a primeira soluçao contendo NaBH4 foi adicionada a segunda soluçao contendo ouro formando uma soluçao vermelha (Figura 1), (característica da formaçao de NPs de ouro). A soluçao de NPs de Au obtida foi analisada em espectrofotômetro UV-Vis e por MET.
 Figura 1. Imagem da dispersao coloidal de NPs de Au obtidas
Aula prática 2: síntese da soluçao biopolimérica e dos filmes biopoliméricos contendo NPs de Au suportadas. Neste experimento, foi preparada uma soluçao contendo 35 mL de acetona e 2,5 g de acetato de celulose, após dissoluçao do acetato de celulose a mistura permaneceu em repouso por 1 h, para obter a viscosidade desejada. Após 1 h os filmes biopoliméricos foram preparados, sendo que foram preparados filmes biopoliméricos sem NPs (denominados de branco, AC) e filmes contendo 10 mg de NPs de Au (denominados AC/Au). A mistura foi imersa em equipamento ultrassom Maxiclean 750A Unique, para dispersao das NPs de Au e depois a soluçao foi vertida em placa de Petri formando os filmes biopoliméricos. Aula prática 3: preparo das placas de Petri contendo cultura de Bactérias E. coli e S. aureus Estas experiências foram realizadas num meio de Luria-Bertani (LB) Agar sólido em uma placa de Petri. Os filmes biopoliméricos liofilizados foram cortados em forma de disco de 1,5 cm de diâmetro, esterilizados por autoclave durante 15 minutos a 120 °C, e colocados em uma placa de Agar contendo bactérias E. coli- cultivadas e em outra placa Agar de bactérias S. aureus- cultivadas. As placas de Petri foram colocadas em incubadora durante 24 h a 37 °C para formaçao dos halos de inibiçao bacteriana. Aula prática 4: avaliaçao dos resultados obtidos Neste experimento as placas de Petri contendo as culturas de bactérias de E. coli e S. aureus incubadas na aula anterior foram analisadas para medir o halo de inibiçao bacteriana formado pelos filmes biopoliméricos contendo NPs de Au suportadas e resultados obtidos foram avaliados. Análises realizadas Espectroscopia na regiao do Ultravioleta-Visível (UV-Vis) O espectro eletrônico da dispersao coloidal de NPs de Au foi realizado utilizando-se um Espectrofotômetro UV-visível modelo UV-2550 da Shimadzu, com leituras na regiao de 190 a 800 cm-1, com celas de quartzo de 1 cm de caminho óptico. Microscopia Eletrônica de Varredura (MEV) As análises por MEV para o estudo da morfologia dos filmes biopoliméricos contendo NPs de Au suportadas foram conduzidas utilizando-se um modelo JEOL JSM 5800 com 10 a 20 kV e magnificaçao de 5000x. Microscopia Eletrônica de Transmissao (MET) A análise de MET das NPs de Au foi realizada utilizando-se um microscópio JEOL JEM1200EXII operando em 120 kv. Para a análise foi utilizada uma amostra das NPs de Au obtidas no experimento. A análise da soluçao coloidal foi realizada com auxílio de pipeta de Pasteur, sobre o grid de cobre (300 mesh) recoberto com uma fina camada de Carbono. Os grids foram colocados em um dessecador para a retirada do solvente e umidade. A contagem das partículas foi feita utilizando o software SigmaScan Pro 5. Os histogramas da distribuiçao foram obtidos usando o programa Origin 8, através da medida do diâmetro de aproximadamente 300 partículas de Au.
RESULTADOS E DISCUSSAO Os experimentos realizados levaram a formaçao de uma dispersao coloidal de NPs de Au, de coloraçao vermelha. A estabilidade da dispersao coloidal de NPs de Au está relacionada a estas permanecerem em suspensao em escala nanométrica, nao ocorrendo aglomeraçao com consequente formaçao de NPs de diâmetro maior. O líquido iônico BMI.PF6 foi utilizado como agente estabilizante das NPs de Au. A presença de líquido iônico causa estabilizaçao eletrostática através do cátion e do ânion, levando a uma repulsao eletrostática entre as NPs e também por estabilizaçao estérea, presença de grupos volumosos, desta forma impedindo a aproximaçao e crescimento das nanopartículas. Os agentes estabilizantes (por ex: líquidos iônicos, sais de amônio quaternário e polímeros) sao utilizados para manter as NPs em escala manométrica, sendo este um fator desafiador nesta área de pesquisa, pois a termodinâmica tende a levar a formaçao de aglomerados metálicos. As técnicas de caracterizaçao utilizadas, ultravioleta-Visível (UV-Vis), microscopia eletrônica de varredura (MEV) e microscopia eletrônica de transmissao (MET) nos fornecem informaçoes a respeito do tamanho, forma e composiçao das NPs de Au e dos filmes biopoliméricos. Estas informaçoes sao de suma importância, pois estao diretamente relacionadas com os resultados obtidos na aplicaçao destas NPs em diversas áreas como, catálise, ótica, médica, farmacêutica, eletroquímica e atividade biológica. A síntese das NPs de ouro coloidal está relacionada à reduçao do Au3+ para Au0 pela açao do boroidreto de sódio como agente redutor, resultando na formaçao de NPs que possuem rede cúbica de face centrada (fcc). Os íons Au3+ sao introduzidos ao meio reacional a partir do ácido tetracloroáurico triidratado, sendo a forma ácida do cloreto de ouro (III). Neste experimento, nao houve aquecimento, muitos trabalhos utilizam o citrato de sódio como agente redutor, sendo o sistema mantido sob aquecimento para favorecer a reduçao do ouro.21 No nosso experimento observou-se a mudança de coloraçao do meio reacional de amarelo para vermelho, que se intensificou até o final da síntese. Após aproximadamente 5 min, a soluçao resultante apresentou uma coloraçao vermelha intensa. Na Figura 2 está representado o espectro da soluçao de NPs de Au, obtidas no experimento, por espectroscopia de UV-visível. A banda de absorçao para a amostra ocorreu em 524 nm. A interaçao entre as NPs metálicas e a luz está relacionada com a ressonância plasmônica. Os Plasmons se assemelham a uma onda vinda da oscilaçao coletiva entre os elétrons das NPs metálicas. Quando há formaçao de um plasmo ocorre a separaçao de cargas elétricas na partícula, em funçao da oscilaçao coletiva dos elétrons. Assim, os elétrons se concentram por curtos períodos de tempo, em uma regiao da partícula. Porém existe uma força restauradora, pois esta é uma condiçao energeticamente desfavorável, fazendo com que os elétrons se distribuam novamente de maneira uniforme, obtendo-se no final uma frequência de oscilaçao eletrônica interna. Quando se incide uma radiaçao nesta soluçao e ela tem a mesma frequência que a dos plasmons tem-se a ressonância plasmônica. Esta ressonância produz intensas oscilaçoes eletrônicas na partícula que serao responsáveis pela absorçao ou espalhamento da radiaçao.14 Ao contrário do ouro em forma de sal ou metálico, que apresentam cor amarelada, o ouro coloidal apresenta coloraçao avermelhada, as NPs de ouro absorvem na regiao de ~500 nm a ~560 nm. Se observarmos o espectro eletromagnético veremos que a regiao que as NPs de ouro absorvem corresponde ao verde, ou seja, elas absorvem o verde e refletem o vermelho.
 Figura 2. Espectro de Uv-vísivel da dispersao coloidal de NPs de Au
As NPs de Au obtidas também foram analisadas por microscopia eletrônica de transmissao (MET). A micrografia e o histograma de distribuiçao de diâmetro médio das partículas obtidas sao expostos na Figura 3. As NPs de Au (Figura 3A) exibiram diâmetro médio de 11 ± 1.5 nm. O histograma de distribuiçao de diâmetro (Figura 3B) foi obtido pela contagem de cerca de 300 partículas em diferentes regioes do grid analisado por MET.
 Figura 3. Micrografia obtida por MET (A) NPs de Au e (B) histograma de distribuiçao de diâmetro das NPs de Au.
A dispersao coloidal vermelha de ouro preparada em líquido iônico BMI.PF6 foi misturada com uma soluçao de acetato de celulose (AC) dissolvida em acetona. A mistura obtida foi vertida em placa de Petri, após 5 min ocorreu à evaporaçao total do solvente e obtiveram-se os filmes biopoliméricos contendo NPs de Au suportadas, denominados AC/Au. Os filmes biopoliméricos contendo NPs de Au suportadas (AC/Au) foram analisados por microscopia eletrônica de varredura (MEV). A Figura 4 expoe a micrografia obtida por MEV. Podemos observar que o filme apresenta estrutura porosa e que pequenos aglomerados de NPs de Au estao distribuídos homogeneamente sobre todo filme biopolimérico.
 Figura 4. Micrografia obtida por MEV de pequenos aglomerados de NPs de Au suportados nos filmes biopoliméricos
A presença do líquido iônico BMI.PF6 ocasiona um afastamento das moléculas de celulose, proporcionando maior maleabilidade e resistência aos filmes biopoliméricos. O filme biopolimérico preparado sem adiçao de líquido iônico BMI.PF6 e NPs (denominado de branco, AC) exibiu aparência frágil e quebradiça. A atividade antibacteriana dos filmes biopoliméricos foi investigada frente a bactérias gram-positivas (S. aureus) e gram-negativas (E.coli) através do método de disco com formaçao de halo de inibiçao. As bactérias S. aureus, sao cocos, gram-positivos, sendo que muitos pertencem à microbiota normal do trato respiratório superior ou da pele. As bactérias E. coli, se referem a gêneros diversos de bactéria bacilar gram-negativa, sendo um parasita intestinal generalizado de mamíferos. A habilidade dos filmes biopoliméricos contendo NPs de Au suportadas em inibir o crescimento destas bactérias está exposto na Figura 5. Nos experimentos utilizamos um disco de 1,5 cm de filme biopolimérico sem a presença NPs de Au (denominado de AC), localizado na esquerda da placa de Petri, e um disco de filme biopolimérico contendo NPs de Au (denominado AC/Au), localizado à direita na placa de Petri.
Figura 5. Atividade Antimicrobiana dos filmes biopoliméricos, AC (Branco, filme sem NPs Au) e AC/Au (filme contendo NPs de Au) frente as Bactérias: (A) E.coli e (B) S. aureus
A açao antibacteriana das NPs metálicas ocorre através da coordenaçao destas a camada superficial das bactérias ocasionando o rompimento da camada de peptidoglicano e consequente inativaçao. O peptidoglicano é a estrutura que confere rigidez à parede celular de bactérias, determina a forma da bactéria e protege da lise osmótica, quando em meio hipotônico. A camada de peptidoglicano da bactéria gram-negativa (E. coli) é mais fina do que nas bactérias gram-positivas (S. aureus),22 provavelmente este fato está relacionado às NPs de Au se coordenarem mais facilmente e eficientemente causando maior inibiçao nas bactérias E. coli do que nas bactérias S. aureus (a formaçao de 5 mm de halo de inibiçao bacteriana foram obtidos para E. coli e 3 mm para S. aureus, Figura 5).22
CONCLUSAO Os experimentos realizados neste estudo, aplicados a alunos de Graduaçao na disciplina de Nanotecnologia possibilitaram o primeiro contato destes com conceitos relacionados à nanociência, um assunto bastante discutido em ciência atualmente. As práticas foram de simples manipulaçao, os reagentes de custo mais alto sao o sal de ouro (HAuCl4.3H2O), e o líquido iônico BMI.PF6, porém as quantidades utilizadas foram pequenas. Seria interessante se cada grupo de alunos obtivesse suas próprias imagens das NPs de Au através da microscopia eletrônica de varredura (MEV) e de transmissao (MET), mas sabemos que isso é impraticável para os cursos de Graduaçao. Porém, de maneira alguma a prática foi prejudicada. Foi importante os alunos terem informaçoes sobre alguns conceitos sobre estas ferramentas fundamentais na caracterizaçao de materiais em escala nanométrica. Os resultados gerados pelos métodos de síntese aplicados, confirmados pelas técnicas de caracterizaçao utilizadas, também contribuíram para que a prática fosse bem sucedida e agregasse conhecimento a respeito dos fenômenos relacionados a sistemas em escala nano para os alunos. A aplicaçao dos filmes biopoliméricos contendo NPs de Au suportadas em inativaçao bacteriana também despertou grande atençao dos alunos, devido a ser um tema sempre atual e resultado de extensa aplicaçao, os filmes biopoliméricos antibacterianos podem ser utilizados como embalagem polimérica para a conservaçao de frutas e alimentos, por exemplo.
AGRADECIMENTOS Aos alunos de graduaçao da disciplina de Nanotecnologia, que foram parte fundamental para o desenvolvimento deste trabalho. Aos alunos Camila Costa de Quadros (aluna do curso de Engenharia de Alimentos), Marcos F. Brunelli (aluno do curso de Química bacharelado) e ao aluno de Mestrado em Química Tecnológica e Ambiental Vinícius W. Faria. Agradecemos à FAPERGS pelas bolsas de iniciaçao científica e a CAPES pela bolsa de pós-graduaçao. Agradecemos também ao CNPq pelo apoio financeiro e a FURG pela oportunidade de desenvolvimento deste trabalho.
REFERENCIAS 1. Hochella-Júnior, M. F.; Earth Planet Sci. Lett. 2002, 203, 593. DOI: http://dx.doi.org/10.1016/S0012-821X(02)00818-X 2. Zhiguang, W.; Tialong, L.; Wei, G.; Adv. Funct. Mater. 2015, 25, 3881. DOI: http://dx.doi.org/10.1002/adfm.201501050 3. Brockson, M. E.; Novotny, L. A.; Mokrzan, E. M.; Malhotra, S.; Jurcisek, J. A.; Akbar, R.; Devaraj, A.; Goodman, S. D.; Bakaletz, L. O.; Mol. Microbiol. 2014, 93, 1246. PMID: 25069521 4. Diban, N.; Stamatialis, D. J.; Chem. Technol. Biotechnol. 2014, 89, 633. DOI: http://dx.doi.org/10.1002/jctb.4300 5. Faria, V. W.; Oliveira, D. G. M.; Kurz, M. H. S.; Gonçalves, F. F.; Rosa, G. R.; Scheeren, C. W.; RSC Advances. 2014, 4, 13446. DOI: http://dx.doi.org/10.1039/c4ra01104j 6. Wang, Q.; Song, W-L.; Fan, L-Z.; Song, Y.; J. Membr. Sci. 2015, 486, 21. DOI: http://dx.doi.org/10.1016/j.memsci.2015.03.062 7. Goh, P. S.; Ng, B. C.; Lau, W. J.; Ismail, A. F.; Separation e Purification Reviews 2015, 44, 216. DOI: http://dx.doi.org/10.1080/15422119.2014.926274 8. Stoimenov, P. K.; Klinger, R. L.; Marchin, G. L.; Klabunde, K. J.; Langmuir 2002, 18, 6679. DOI: http://dx.doi.org/10.1021/la0202374 9. Balogh, L.; Swanson, D. R.; Tomalia, D. A.; Hagnauer, G. L.; McManus, A. T.; Nano Lett. 2001, 1, 18. DOI: http://dx.doi.org/10.1021/nl005502p 10. Kasuga, T.; Kume, H.; Abe, Y.; J. Am. Ceram. Soc. 1997, 80, 777. DOI: http://dx.doi.org/10.1111/j.1151-2916.1997.tb02898.x 11. Kasuga, T.; Kume, H.; Abe, Y.; J. Am. Ceram. Soc. 1999, 82, 65. 12. Yang, M. R.; Chem, K. S.; Rsai, J. C.; Tseng, C. C.; Lin, S. F.; Mater. Sci. Eng., C. 2002, 20, 167. DOI: http://dx.doi.org/10.1016/S0928-4931(02)00028-0 13. Scheeren, C. W.; Hermes, V.; Bianchi, O.; Hertz, P.; Dias, S. L. P.; Dupont, J.; J Nanosci. Nanotechnol. 2011, 11, 5114. DOI: http://dx.doi.org/10.1166/jnn.2011.4117 PMID: 21770152 14. Kwak, S. Y.; Kim, S. H.; Kim, S. S.; Environ. Sci. Technol. 2001, 35, 2388. DOI: http://dx.doi.org/10.1021/es0017099 PMID: 11414050 15. Kierans, M.; Staines, A. M.; Bennett, H.; Gadd, G. M.; Biology of Metals 1991, 4, 100. DOI: http://dx.doi.org/10.1007/BF01135386 PMID: 1878280 16. Ciriolo, M. R.; Civitareale, P.; Carri, M. T.; De Martino, A.; Galiazzo, F.; Rotilio, G.; J. Biol. Chem. 1994, 269, 25783. PMID: 7929283 17. Edgar, K. J.; Buchanan, C. M.; Debenham, J. S.; Prog. Polym. Sci. 2001, 26, 1605. DOI: http://dx.doi.org/10.1016/S0079-6700(01)00027-2 18. Viswanathan, G.; Murugesan, S.; Pushparaj, V.; Nalamasu, O.; Ajayan, P. M.; Linhardt, R. J.; Biomacromolecules 2006, 7, 415. DOI: http://dx.doi.org/10.1021/bm050837s PMID: 16471910 19. Xu, J.; Dozier, A.; Bhattacharyya, D.; J. Nanop. Res. 2005, 7, 449 DOI: http://dx.doi.org/10.1007/s11051-005-4273-3 20. Gelesky, M. A.; Scheeren, C. W.; Polímeros-Ciência e Tecnologia 2014, 24, 1. DOI: http://dx.doi.org/10.1590/0104-1428.ed06 21. Daniel, M.; Astruc, D.; Chem. Rev. 2004, 104, 293 DOI: http://dx.doi.org/10.1021/cr030698+ PMID: 14719978 22. Bastús, N. G.; Comenge, J.; Puntes, V.; Langmuir 2011, 27, 11098. |
On-line version ISSN 1678-7064 Printed version ISSN 0100-4042
Qu�mica Nova
Publica��es da Sociedade Brasileira de Qu�mica
Caixa Postal: 26037
05513-970 S�o Paulo - SP
Tel/Fax: +55.11.3032.2299/+55.11.3814.3602
Free access





